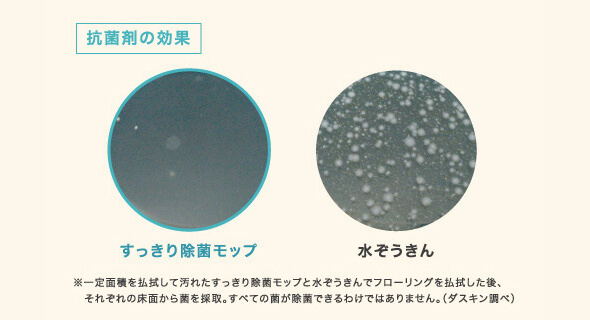

すっきり除菌モップ
特徴
月1・2回のお手入れでおうちの床の清潔&キレイを守れます
普段はフロアモップでホコリ取りをして、月に1、2回は除菌モップでしっかり除菌。2つのモップを使いこなせば、いつでも清潔&キレイをキープできます。
1枚でたっぷり!両面使えて約12~18畳のおそうじに対応
1枚で約12~18畳分のおそうじに使えてお得。モップに湿り気があれば、フロアに液がつかなくても汚れがとれるので、床にもやさしく使えます。
極細繊維と独自の洗浄成分の力で簡単・キレイに汚れが落とせる!
立体格子柄にした独自の繊維が軽いホコリやゴミまでキャッチ。エタノール、界面活性剤、抗菌剤、消臭剤を配合しているので、ひと拭きで一気に汚れを落とせます。
雑菌、ニオイ、アレル物質もしっかり除去!
水拭きで落としきれない雑菌、ニオイ、アレル物質(ダニ・花粉)もすっきり拭き取れるから、床を衛生的に保てます。抗菌剤の効果で、汚れた床を拭くときも、菌が塗り広がることはありません。